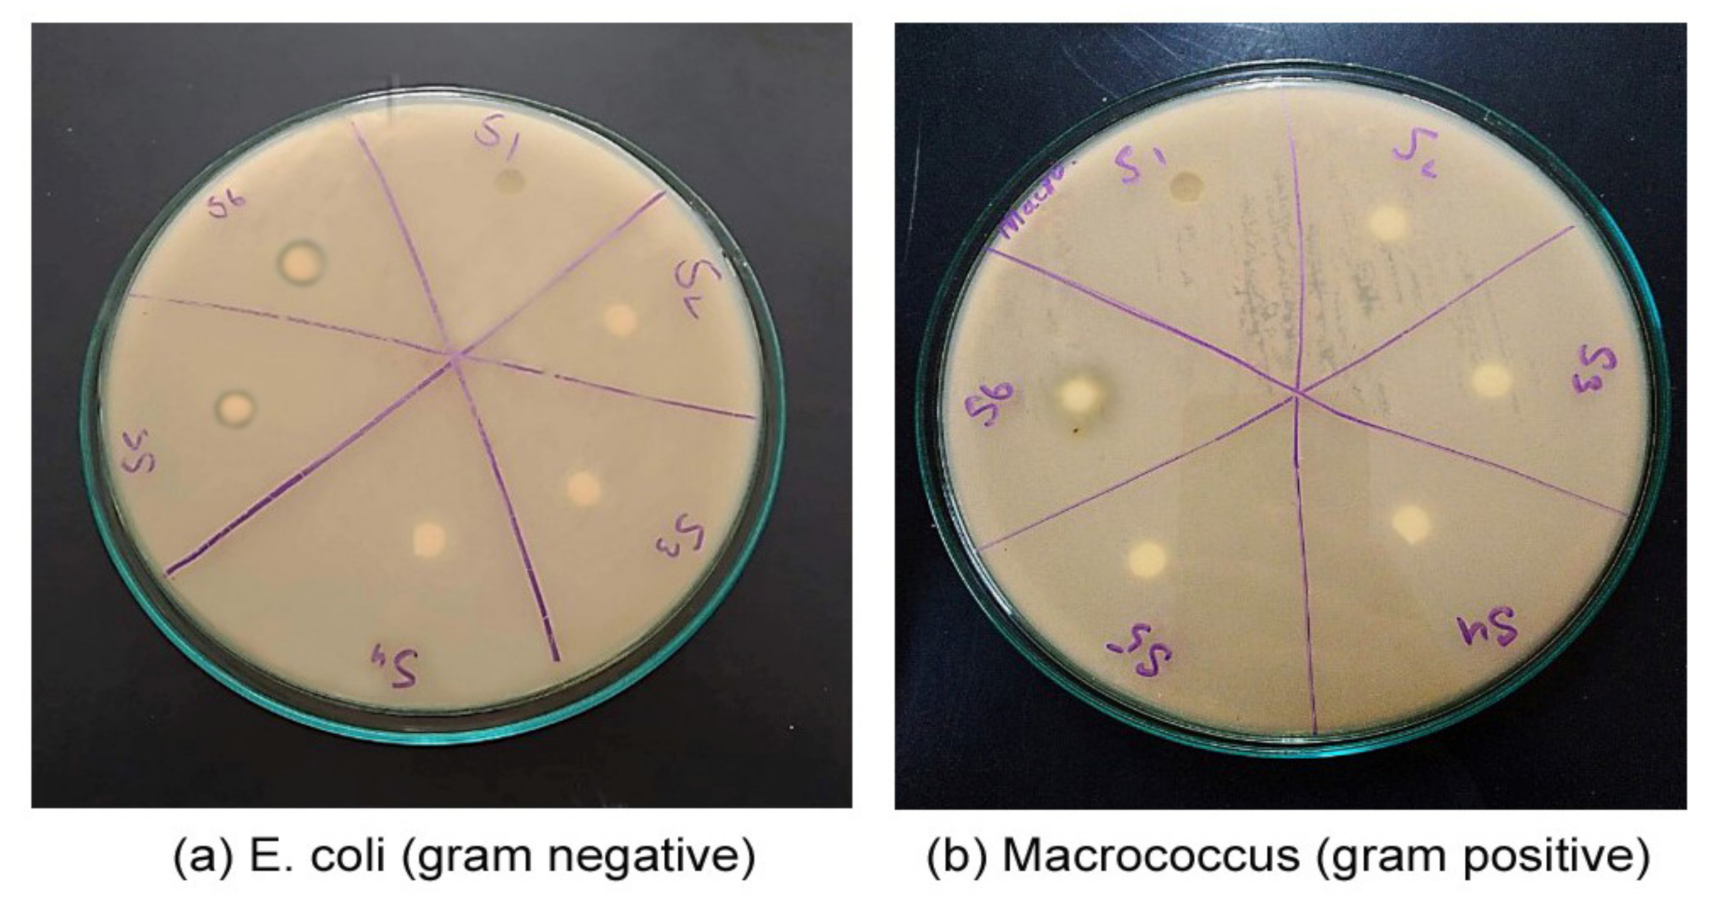
Polymers 13 03416 g004 550
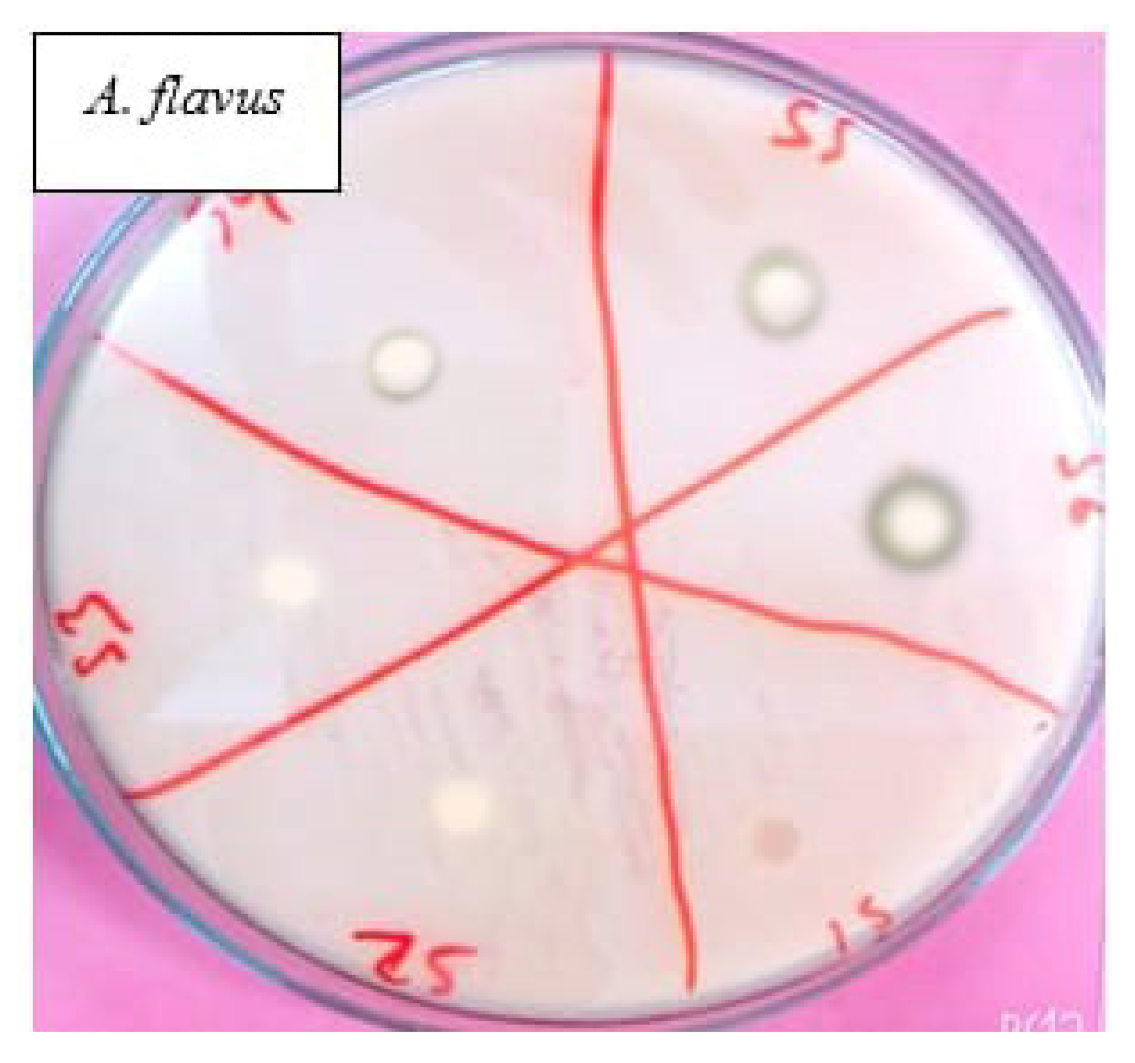
Polymers 13 03416 g005 550

Synthesis and Study of Morphology and Biocompatibility of Xanthan Gum/Titanium Dioxide-Based Polyurethane Elastomers
Abstract
:1. Introduction
2. Experimental
2.1. Materials and Synthesis
2.2. Synthesis of Final Polymer
3. Characterization
3.1. Fourier Transform Infrared Spectroscopy (FT-IR)
3.2. Atomic Force Microscopy (AFM)
3.3. Thermogravimetric (TGA) and Differential Scanning Calorimeter (DSC)
3.4. Antimicrobial Activity
3.5. X-ray Diffractometry (XRD)
4. Results and Discussion
4.1. FT-IR Analysis
4.2. Evaluation of Antimicrobial Activity
4.2.1. Evaluation of Antibacterial Activity
4.2.2. Evaluation of Antifungal Activity
4.3. Thermal Analysis
4.3.1. Thermogravimetric Analysis (TGA)
4.3.2. Differential Scanning Calorimetry (DSC) Study
4.4. X-Ray Diffraction Study
4.5. Atomic Force Microscopy (AFM)
4.6. Evaluation of Water Absorption
5. Conclusions
Author Contributions
Funding
Institutional Review Board Statement
Informed Consent Statement
Data Availability Statement
Conflicts of Interest
References
- Zhang, Z.-G.; Chen, H.-Z. Xanthan production on polyurethane foam and its enhancement by air pressure pulsation. Appl. Biochem. Biotech. 2010, 162, 2244–2258. [Google Scholar] [CrossRef]
- Klinedinst, D.B.; Yilgör, E.; Yilgör, I.; Beyer, F.L.; Wilkes, G.L. Structure–property behavior of segmented polyurethaneurea copolymers based on an ethylene-butylene soft segment. Polymer 2005, 46, 10191–10201. [Google Scholar] [CrossRef]
- Hottle, T.A.; Bilec, M.M.; Landis, A.E. Sustainability assessments of bio-based polymers. Polym. Degrad. Stab. 2013, 98, 1898–1907. [Google Scholar] [CrossRef]
- Huang, S.L.; Chao, M.S.; Ruaan, R.C.; Lai, J.Y. Microphase separated structure and protein adsorption of polyurethanes with butadiene soft segment. Eur. Polym. J. 2000, 36, 285–294. [Google Scholar] [CrossRef]
- Ishihara, K.; Iwasaki, Y. Biocompatible elastomers composed of segmented polyurethane and 2-methacryloyloxyethyl phosphorylcholine polymer. Polym. Adv. Technol. 2000, 11, 626–634. [Google Scholar] [CrossRef]
- Zia, K.M.; Zuber, M.; Bhatti, I.A.; Barikani, M.; Sheikh, M.A. Evaluation of biocompatibility and mechanical behavior of polyurethane elastomers based on chitin/1, 4-butane diol blends. Int. J. Biol. Macromol. 2009, 44, 18–22. [Google Scholar] [CrossRef] [PubMed]
- Middleton, J.C.; Tipton, A.J. Synthetic biodegradable polymers as orthopedic devices. Biomaterials 2000, 21, 2335–2346. [Google Scholar] [CrossRef]
- Wang, Y.; Hong, Q.; Chen, Y.; Lian, X.; Xiong, Y. Surface properties of polyurethanes modified by bioactive polysaccharide-based polyelectrolyte multilayers. Colloids Surfaces B Biointerfaces 2012, 100, 77–83. [Google Scholar] [CrossRef] [PubMed]
- Zhou, B.; Hu, Y.; Li, J.; Li, B. Chitosan/phosvitin antibacterial films fabricated via layer-by-layer deposition. Int. J. Boil. Macromol. 2014, 64, 402–408. [Google Scholar] [CrossRef]
- Szycher, M. Szycher’s Handbook of Polyurethanes, 2nd ed.; CRC Press: Boca Raton, FL, USA, 2012. [Google Scholar]
- Gaidukova, G.; Ivdre, A.; Fridrihsone, A.; Verovkins, A.; Cabulis, U.; Gaidukovs, S. Polyurethane rigid foams obtained from polyols containing bio-based and recycled components and functional additives. Ind. Crop. Prod. 2017, 102, 133–143. [Google Scholar] [CrossRef]
- Kuan, H.; Ma, C.-C.M.; Chang, W.-P.; Yuen, S.-M.; Wu, H.-H.; Lee, T.-M. Synthesis, thermal, mechanical and rheological properties of multiwall carbon nanotube/waterborne polyurethane nanocomposite. Compos. Sci. Technol. 2005, 65, 1703–1710. [Google Scholar] [CrossRef]
- Zia, K.M.; Bhatti, H.N.; Bhatti, I.A. Methods for polyurethane and polyurethane composites, recycling and recovery: A review. React. Funct. Polym. 2007, 67, 675–692. [Google Scholar] [CrossRef]
- Hu, Y.; Liu, C.; Shang, Q.; Zhou, Y. Synthesis and characterization of novel renewable castor oil-based UV-curable polyfunctional polyurethane acrylate. J. Coatings Technol. Res. 2017, 15, 77–85. [Google Scholar] [CrossRef]
- Nair, L.S.; Laurencin, C.T. Biodegradable polymers as biomaterials. Prog. Polym. Sci. 2007, 32, 762–798. [Google Scholar] [CrossRef]
- Gorna, K.; Gogolewski, S. Molecular stability, mechanical properties, surface characteristics and sterility of biodegradable polyurethanes treated with low-temperature plasma. Polym. Degrad. Stab. 2003, 79, 475–485. [Google Scholar] [CrossRef]
- Barikani, M.; Hepburn, C. The relative thermal stability of polyurethane elastomers. II: Influence of polyol-diisocyanate molar block ratios with a single and mixed diisocyanate system. Cell. Polym. 1987, 6, 29–36. [Google Scholar]
- Tant, M.R.; McManus, H.L.N.; Rogers, M.E. High-Temperature Properties and Applications of Polymeric Materials; ACS Publications: Washington, DC, USA, 1995; pp. 1–20. [Google Scholar] [CrossRef]
- Bhattacharyya, A.; Mukherjee, D.; Mishra, R.; Kundu, P. Preparation of polyurethane–alginate/chitosan core shell nanoparticles for the purpose of oral insulin delivery. Eur. Polym. J. 2017, 92, 294–313. [Google Scholar] [CrossRef]
- Freitas, F.; Alves, V.D.; Reis, M.A. Advances in bacterial exopolysaccharides: From production to biotechnological applications. Trends Biotech. 2011, 29, 388–398. [Google Scholar] [CrossRef] [PubMed]
- Gultekin, G.; Atalay-Oral, C.; Erkal, S.; Sahin, F.; Karastova, D.; Tantekin-Ersolmaz, S.B.; Guner, F.S. Fatty acid-based polyurethane films for wound dressing applications. J. Mater. Sci. Mater. Electron. 2008, 20, 421–431. [Google Scholar] [CrossRef] [PubMed] [Green Version]
- Usuki, A.; Kojima, Y.; Kawasumi, M.; Okada, A.; Fukushima, Y.; Kurauchi, T.; Kamigaito, O. Synthesis of nylon 6-clay hybrid. J. Mater. Res. 1993, 8, 1179–1184. [Google Scholar] [CrossRef]
- Yurekli, K.; Karim, A.; Amis, E.J.; Krishnamoorti, R. Influence of Layered Silicates on the Phase-Separated Morphology of PS−PVME Blends. Macromolecules 2003, 36, 7256–7267. [Google Scholar] [CrossRef]
- Jabbari, E.; Khakpour, M. Morphology of and release behavior from porous polyurethane microspheres. Biomaterials 2000, 21, 2073–2079. [Google Scholar] [CrossRef]
- Naheed, S.; Zuber, M.; Barikani, M.; Salman, M. Molecular engineering and morphology of polyurethane elastomers containing various molecular weight of macrodiol. Mater. Sci. Eng. B 2020, 264, 114960. [Google Scholar] [CrossRef]
- Standard Test Method for Isocyanate Groups in Urethane Materials or Prepolymers; ASTM D2572-80; ASTM: West Conshohocken, PA, USA, 2010.
- Yilgör, I.; Yilgor, E.; Das, S.; Wilkes, G.L. Time-dependent morphology development in segmented polyetherurea copolymers based on aromatic diisocyanates. J. Polym. Sci. Part B Polym. Phys. 2009, 47, 471–483. [Google Scholar] [CrossRef]
- Hsu, S.-H.; Tseng, H.-J.; Lin, Y.-C. The biocompatibility and antibacterial properties of waterborne polyurethane-silver nanocomposites. Biomaterials 2010, 31, 6796–6808. [Google Scholar] [CrossRef]
- Yilgor, I.; Yilgor, E.; Guler, I.G.; Ward, T.C.; Wilkes, G.L. FTIR investigation of the influence of diisocyanate symmetry on the morphology development in model segmented polyurethanes. Polymer 2006, 47, 4105–4114. [Google Scholar] [CrossRef]
- Naz, F.; Zuber, M.; Zia, K.M.; Salman, M.; Chakraborty, J.; Nath, I.; Verpoort, F. Synthesis and characterization of chitosan-based waterborne polyurethane for textile finishes. Carbohydr. Polym. 2018, 200, 54–62. [Google Scholar] [CrossRef]
- Tabasum, S.; Zuber, M.; Jamil, T.; Shahid, M.; Hussain, R. Antimicrobial and pilling evaluation of the modified cellulosic fabrics using polyurethane acrylate copolymers. Int. J. Biol. Macromol. 2013, 56, 99–105. [Google Scholar] [CrossRef]
- Barrioni, B.R.; de Carvalho, S.M.; Oréfice, R.L.; de Oliveira, A.A.R.; Pereira, M.D.M. Synthesis and characterization of biodegradable polyurethane films based on HDI with hydrolyzable crosslinked bonds and a homogeneous structure for biomedical applications. Mater. Sci. Eng. C 2015, 52, 22–30. [Google Scholar] [CrossRef]
- Azzam, R.A.; Mohamed, S.K.; Tol, R.; Everaert, V.; Reynaers, H.; Goderis, B. Synthesis and thermo-mechanical characterization of high performance polyurethane elastomers based on heterocyclic and aromatic diamine chain extenders. Polym. Degrad. Stab. 2007, 92, 1316–1325. [Google Scholar] [CrossRef]
- Malakpour, S.E.; Rostamizadeh, H. Synthesis of novel polyurethanes with Fluorescein Linkages. Iran. Polym. J. 1999, 8, 099V. [Google Scholar]
- Travinskaya, T.V.; Brykova, A.N.; Savelyev, Y.V.; Babkina, N.V.; Shtompel, V.I. (Bio) degradable ionomeric polyurethanes based on xanthan: Synthesis, properties, and structure. Inter. J. Polym Sci. 2017, 103, 903–908. [Google Scholar] [CrossRef] [Green Version]
- Chen, M.; Zhou, D.-L.; Chen, Y.; Zhu, P.-X. Analyses of structures for a synthetic leather made of polyurethane and microfiber. J. Appl. Polym. Sci. 2006, 103, 903–908. [Google Scholar] [CrossRef]
- Naheed, S.; Zuber, M.; Salman, M.; Rasool, N.; Siddique, Z.; Shaik, M.; Sharaf, M.; Abdelgawad, A.; Sekou, D.; Awwad, E. Impact of Macrodiols on the Morphological Behavior of H12MDI/HDO-Based Polyurethane Elastomer. Polymers 2021, 13, 2060. [Google Scholar] [CrossRef]
- Yang, C.-H.; Liu, F.-J.; Liu, Y.-P.; Liao, W.-T. Hybrids of colloidal silica and waterborne polyurethane. J. Colloid Interface Sci. 2006, 302, 123–132. [Google Scholar] [CrossRef]
- da Silva, V.D.; dos Santos, L.M.; Subda, S.M.; Ligabue, R.; Seferin, M.; Carone, C.L.P.; Einloft, S. Synthesis and characterization of polyurethane/titanium dioxide nanocomposites obtained by in situ polymerization. Polym. Bull. 2013, 70, 1819–1833. [Google Scholar] [CrossRef]
- Asensio, M.; Costa, V.; Nohales, A.; Bianchi, O.; Gómez, A.C.M. Tunable Structure and Properties of Segmented Thermoplastic Polyurethanes as a Function of Flexible Segment. Polymers 2019, 11, 1910. [Google Scholar] [CrossRef] [Green Version]
- Naheed, S.; Zuber, M.; Barikani, M. Synthesis and thermo-mechanical investigation of macrodiol-based shape memory polyurethane elastomers. Int. J. Mater. Res. 2017, 108, 515–522. [Google Scholar] [CrossRef]

| Sample Code | IPDI (mole) | HTPB (mole) | BDO (mole) | TiO2 % | Xanthan Gum % |
|---|---|---|---|---|---|
| XTPU-1 | 2 | 0.8 | 1.2 | 0 | 0 |
| XTPU-2 | 2 | 0.8 | 1.2 | 1 | 1 |
| XTPU-3 | 2 | 0.8 | 1.2 | 2 | 1 |
| XTPU-4 | 2 | 0.8 | 1.2 | 3 | 1 |
| XTPU-5 | 2 | 0.8 | 1.2 | 4 | 1 |
| XTPU-6 | 2 | 0.8 | 1.2 | 5 | 1 |
| Sample Code | IPDI (mole) | HTPB (mole) | BDO (mole) | TiO2 % | X.G % | T0 (°C) | T20 (°C) | T50 (°C) | T80 (°C) | T max (°C) |
|---|---|---|---|---|---|---|---|---|---|---|
| XTPU-1 | 2 | 0.8 | 1.2 | 0 | 0 | 140 | 372 | 423 | 448 | 460 |
| XTPU-2 | 2 | 0.8 | 1.2 | 1 | 1 | 150 | 380 | 430 | 470 | 479 |
| XTPU-3 | 2 | 0.8 | 1.2 | 2 | 1 | 162 | 385 | 435 | 475 | 485 |
| XTPU-4 | 2 | 0.8 | 1.2 | 3 | 1 | 190 | 372 | 455 | 479 | 487 |
| XTPU-5 | 2 | 0.8 | 1.2 | 4 | 1 | 210 | 390 | 457 | 482 | 489 |
| XTPU-6 | 2 | 0.8 | 1.2 | 5 | 1 | 225 | 405 | 467 | 485 | 495 |
| Sample Code | IPDI (mole) | HTPB (mole) | BDO (mole) | TiO2 % | X.G % | Tg (°C) | Tc (°C) | Tm (°C) | Td (°C) |
|---|---|---|---|---|---|---|---|---|---|
| XTPU-1 | 2 | 0.8 | 1.2 | 0 | 0 | 178 | 368 | 430 | 460 |
| XTPU-2 | 2 | 0.8 | 1.2 | 1 | 1 | 180 | 365 | 435 | 479 |
| XTPU-3 | 2 | 0.8 | 1.2 | 2 | 1 | 183 | 370 | 435 | 485 |
| XTPU-4 | 2 | 0.8 | 1.2 | 3 | 1 | 185 | 370 | 440 | 487 |
| XTPU-5 | 2 | 0.8 | 1.2 | 4 | 1 | 191 | 371 | 447 | 489 |
| XTPU-6 | 2 | 0.8 | 1.2 | 5 | 1 | 193 | 373 | 450 | 495 |
| Sr. No | Samples Code | Temperature (°C) | % Age of Water Absorption | ||||
|---|---|---|---|---|---|---|---|
| Day 1 | Day 2 | Day 3 | Day 4 | Day 5 | |||
| 01 | XTPU-1 | 37 | 0.94 | 0.95 | 0.98 | 1.10 | 1.21 |
| 02 | XTPU-2 | 37 | 0.95 | 0.96 | 0.99 | 1.10 | 1.23 |
| 03 | XTPU-3 | 37 | 0.95 | 0.98 | 1.10 | 1.21 | 1.31 |
| 04 | XTPU-4 | 37 | 1.10 | 1.20 | 1.3 | 1.5 | 1.61 |
| 05 | XTPU-5 | 37 | 1.80 | 1.85 | 1.90 | 1.95 | 1.99 |
| 06 | XTPU-6 | 37 | 1.96 | 1.98 | 1.99 | 2.0 | 2.1 |
Publisher’s Note: MDPI stays neutral with regard to jurisdictional claims in published maps and institutional affiliations. |
© 2021 by the authors. Licensee MDPI, Basel, Switzerland. This article is an open access article distributed under the terms and conditions of the Creative Commons Attribution (CC BY) license (https://creativecommons.org/licenses/by/4.0/).
Share and Cite
Naheed, S.; Shahid, M.; Zahoor, R.; Siddique, Z.; Rasool, N.; Haider, S.; Khan, S. Synthesis and Study of Morphology and Biocompatibility of Xanthan Gum/Titanium Dioxide-Based Polyurethane Elastomers. Polymers 2021, 13, 3416. https://doi.org/10.3390/polym13193416
Naheed S, Shahid M, Zahoor R, Siddique Z, Rasool N, Haider S, Khan S. Synthesis and Study of Morphology and Biocompatibility of Xanthan Gum/Titanium Dioxide-Based Polyurethane Elastomers. Polymers. 2021; 13(19):3416. https://doi.org/10.3390/polym13193416
Chicago/Turabian StyleNaheed, Shazia, Muhammad Shahid, Rashida Zahoor, Zumaira Siddique, Nasir Rasool, Sajjad Haider, and Shaukat Khan. 2021. "Synthesis and Study of Morphology and Biocompatibility of Xanthan Gum/Titanium Dioxide-Based Polyurethane Elastomers" Polymers 13, no. 19: 3416. https://doi.org/10.3390/polym13193416
APA StyleNaheed, S., Shahid, M., Zahoor, R., Siddique, Z., Rasool, N., Haider, S., & Khan, S. (2021). Synthesis and Study of Morphology and Biocompatibility of Xanthan Gum/Titanium Dioxide-Based Polyurethane Elastomers. Polymers, 13(19), 3416. https://doi.org/10.3390/polym13193416

